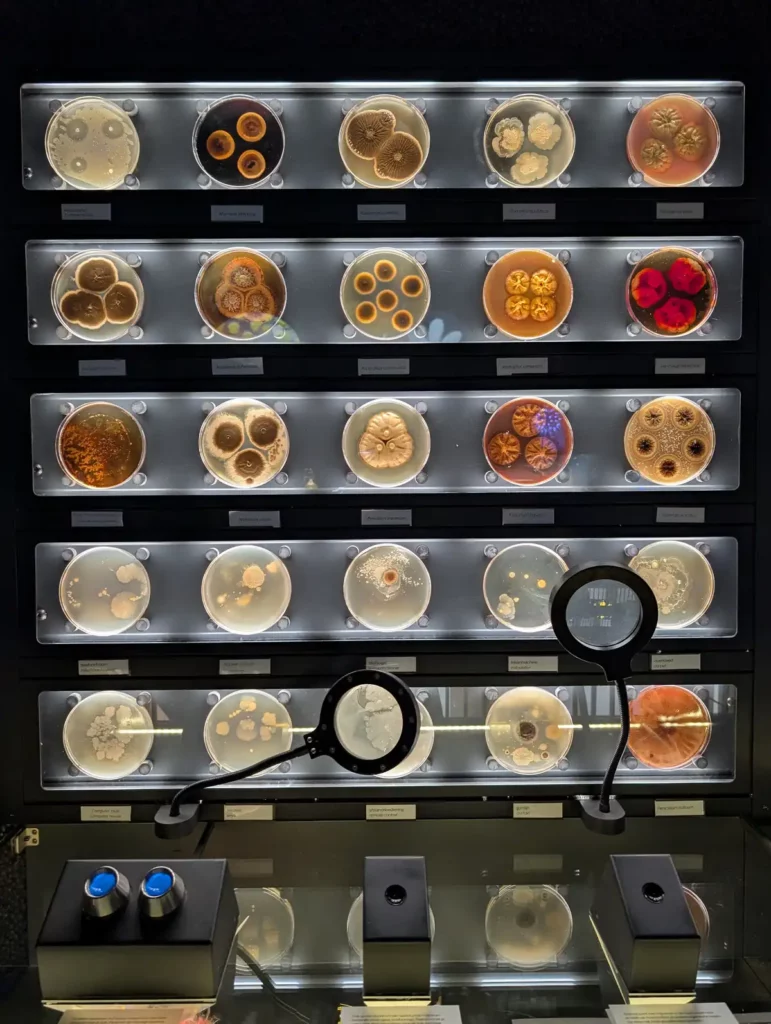

Amsterdam has more than 70 museums, ranging from world-famous galleries to quirky little collections. You could spend weeks working your way around them all, but if you only have a short trip then you’ll need to prioritise.
To help you plan your trip, here are the best museums in Amsterdam; from the unmissable highlights like the Rijksmuseum to my personal favourites and unusual spots you might not have heard of.

I’ve also included tips on how to book tickets, because some of these museums sell out quickly, plus some suggestions for how to group museums together by area to make the most of your time in Amsterdam.
I’ve visited all these museums personally so let me know in the comments if you have any questions!
Contents
Rijksmuseum

The Rijksmuseum is the Netherlands’ national museum and the most important art museum in the country. Inside, you’ll find an incredible collection of paintings, sculptures, ceramics and artefacts spanning 800 years of Dutch history.
The museum’s star attraction is Rembrandt’s Night Watch, but don’t miss Vermeer’s Milkmaid, the Delftware ceramics and the magical and surprisingly difficult to find library. The last time I visited, I’d just read The Miniaturist, so I was particularly keen to see the dolls houses, with all their tiny, astonishing details. The building itself is also stunning, with beautiful vaulted galleries and stained glass windows.

How to get there: The Rijksmuseum is just south of the city centre canal ring on Museumplein, near the Van Gogh Museum, Moco and the Stedelijk Museum. The nearest tram stops are Rijksmuseum and Museumplein. Google maps link.
Ticket information: Tickets are timed and need to be booked in advance on the Rijksmuseum website, even if you’re using the I amsterdam city card. Entry is free with the I amsterdam card or €25 without.
Tips for visiting: If you can, book the first morning slot; you’ll have the Night Watch almost to yourself. Be aware that the Rijksmuseum is huge and you’ll definitely get lost! The excellent free app will help you get to the highlights – bring your own headphones.
Read more: Is the I amsterdam city card worth it? Full review with prices and value
Van Gogh Museum

Just across Museumplein from the Rijksmuseum, the Van Gogh Museum is one of Amsterdam’s busiest attractions. It tells the story of Vincent van Gogh’s life and work, from his early sketches to masterpieces like Sunflowers, The Bedroom and Almond Blossom.
The galleries are arranged chronologically, so you can see how Van Gogh’s style developed and learn more about the struggles he faced.

How to get there: The Van Gogh Museum is on Museumplein, near the Rijksmuseum. You can take a tram to either the Rijksmuseum or Museumplein stops. Google Maps link.
Ticket information: The Van Gogh Museum is one of the few museums in Amsterdam where the I amsterdam city card isn’t valid, so tickets will set you back €24 per person. Under 18s get in free.
Tips for visiting: You’ll need to book your ticket at least 3 to 4 weeks before your visit to be sure of getting in, although if there are only one or two of you you might get lucky a few days in advance.
While the artworks are obviously stunning, I found the crowds detracted from the experience a bit, and the museum’s low ceilings can feel slightly oppressive. If you can, I recommend booking one of the first slots so you can have a more peaceful experience.
I also recommend getting the audio tour; I’m not normally the biggest fan of audio tours but it was really helpful in a busy museum to be able to stand back and listen rather than needing to get close to the displays.
Read my full guide to visiting the Van Gogh Museum in Amsterdam
Anne Frank House

Few museums are as moving as the Anne Frank House. This is where Anne Frank and her family hid from the Nazis during World War II, and where she wrote her famous diary.
Walking through the narrow, cramped rooms of the Secret Annexe brings her story to life in a way that words on a page can’t. I first visited the Anne Frank House in my early teens, so I was close to the age Anne was when she was writing her diary. Needless to say, it was a very moving experience.
The Anne Frank House museum also includes exhibitions on discrimination and human rights, making it one of the most thought-provoking places to visit in Amsterdam.

How to get there: While Anne’s secret annexe was at Prinsengracht 263, the entrance to the museum is around the corner on Westermarkt. The nearest tram stop is Westermarkt. Google Maps link.
Ticket information: Tickets are only sold online via the official website and cost €16.00 for adults. They’re released every Tuesday for visits six weeks ahead, and they sell out extremely quickly, so it’s important to plan ahead.
Tips for visiting: If you don’t manage to get tickets, you can still see the outside of the house at Prinsengracht 263 and visit the Anne Frank memorial outside the Westertoren church a few doors down. If you have time, I also recommend visiting the Dutch Resistance Museum.
Stedelijk Museum

Next door to the Van Gogh Museum is the Stedelijk, Amsterdam’s museum of modern and contemporary art. Its collection covers painting, sculpture, design and applied arts from the late 19th century to today. I still can’t pronounce its name despite very patient Dutch friends trying to teach me, but it’s well worth a visit.
The Stedelijk Museum includes works by big names like Picasso, Mondrian and Kandinsky, alongside Andy Warhol’s pop art and striking contemporary installations.

How to get there: The Stedelijk Museum is another one on Museumplein, near the Rijksmuseum, Van Gogh Museum and Moco. The nearest tram stop is Museumplein, just a couple of minutes’ walk from the museum. Google Maps link.
Ticket information: Entry is free with the I amsterdam City Card. If you don’t have an I amsterdam card, entry costs €22.50 for adults. In general you won’t need to book a slot to see the permanent collection but some temporary exhibitions do require advance booking.
Tips for visiting: The Stedelijk is much less busy than the Van Gogh Museum or Rijksmuseum, and with its spacious atrium and high ceilings, there’s plenty of space and quiet to really take in the exhibits. On my last trip to Amsterdam I visited the Stedelijk straight after the Van Gogh Museum and found it a really lovely, peaceful experience – I had most of the rooms completely to myself! I also liked the first floor cafe, which had great coffee overlooking the busy street outside.
Foam Photography Museum

Set in a canal-side house on the Keizersgracht, Foam is Amsterdam’s leading photography museum. Its exhibitions change regularly, showcasing everything from photojournalism to experimental art. When I visited there was an exhibition by fashion and advertising photographer Carlijn Jacobs exploring themes of AI.

It’s a great place to discover new photographers, and because the exhibitions rotate with up to four at any one time, you’ll always see something different.
How to get there: Foam is on the Keizersgracht in the southern section of the canal ring. The nearest tram stops are Muntplein and Keizersgracht. Google Maps link.
Ticket information: Tickets can be booked online and cost €16.00 for adults. Entry is free with the I amsterdam city card.
Tips for visiting: Unlike most other Amsterdam museums that close at 5pm, the Foam Photography Museum is open until 6pm 5 days a week and 9pm on Thursdays and Fridays.
Eye Filmmuseum

Across the water from Centraal Station, the Eye Filmmuseum is unmissable thanks to its futuristic white building. Inside, the permanent exhibition explores the history of film with vintage cameras, projectors and film clips.
I loved the lower level where you can explore over 100 years of film fragments using a big video wall, and the mini cinemas where two or three people can choose a film to watch together. There are also temporary exhibitions (at the moment there’s a major Tilda Swinton retrospective) and four cinemas showing everything from classics to new releases.

How to get there: Eye Filmmuseum is just over the IJ river from Centraal Station in the Amsterdam Noord area. The free Buiksloterweg ferry from behind Centraal Station takes you there in just five minutes. Google Maps link.
Ticket information: Tickets for the permanent museum collection are free with the I amsterdam city card or €16.00 without. There’s a small extra fee for some exhibitions.
Tips for visiting: The Eye Filmmuseum has one of the best museum cafes in Amsterdam, with floor-to-ceiling windows looking out over the IJ river and a large terrace. It’s a lovely spot to take a break.
NEMO Science Museum

If you’re visiting Amsterdam with kids, the NEMO Science Museum is the place to go, although there’s plenty for adults too. This huge science centre looks like a giant green ship, and inside you’ll find five floors of interactive exhibits. You can try out experiments, join workshops and watch live demonstrations.
Don’t miss heading up to the top floor cafe with doors open to the sloping rooftop square, which is free to visit and has some of the best views over Amsterdam.
To see everything properly, you’ll want to give yourself at least 2-3 hours.

How to get there: NEMO is on the Oosterdok, a 14 minute walk or 14 minute bus from Centraal Station. Google Maps link.
Ticket information: NEMO is very popular, so it’s best to book tickets in advance, especially at weekends and during school holidays. Entry is free with an I amsterdam city card or €21.50 without.
Tips for your visit: Try to catch one of the demonstrations. I saw one on chain reactions which was all in Dutch and aimed at kids, but it was so entertaining, with office chairs sliding through the air, balloons popping and lots of audience participation.
National Maritime Museum (Het Scheepvaartmuseum)

Housed in a 17th-century naval storehouse, the National Maritime Museum (Het Scheepvaartmuseum) explores the Netherlands’ seafaring history. The exhibits include ship models, old maps and navigation instruments, as well as stories of trade, exploration and naval power.
The highlight for me was the full-size replica of the Dutch East India Company ship Amsterdam, which you can climb aboard to see what life was like on a Dutch trading vessel. You can also see the 200-year-old Dutch Royal Barge in a specially constructed boathouse.
On sunny days, the light coming through the huge glass roof in the old warehouse’s courtyard makes beautiful patterns on the walls.

How to get there: The Maritime Museum is on the edge of the Oosterdok near NEMO. The nearest bus stop is Kadijksplein. Google Maps link.
Ticket information: There’s no need to book a timed entry slot at Het Scheepvaartmuseum. Entry is free with the I amsterdam city card or € 18.50 for adults.
Tips for visiting: During bad weather access to the Amsterdam ship might be restricted, but I visited during some very blustery and stormy weather and was able to go aboard.
ARTIS-Groote Museum

Part of the ARTIS complex which includes the ARTIS Zoo, the ARTIS-Groote Museum is a natural history museum housed in Amsterdam’s oldest museum building. Closed since 1947, it reopened in 2022 after a major renovation and reimagining of what a natural history museum should be in the 21st century.
Rather than showing the differences between humans, animals and plants, ARTIS-Groote Museum explores our place in the natural world, with interactive exhibits and intriguing displays. My favourite part of the museum was the interactive spine analyser which got you to move your spine in front of a display and then matched you with an animal – I kept getting a wiggly salamander!

How to get there: The ARTIS complex is in the lovely De Plantage district just east of the city centre, with lots of other museums and attractions nearby. The nearest tram stop is Artis/Holocaust Museum. Google Maps link.
Ticket information: The ARTIS-Groote Museum is included in the I amsterdam city card with no need to book a timeslot in advance. If you don’t have an I amsterdam card, an adult ticket costs €17.50; there are discounts for visiting two or more ARTIS attractions.
Tips for visiting: ARTIS-Groote Museum has regular drop-in workshops and group activities. When I visited, I took part in a ‘Food for the Future’ workshop.
ARTIS-Micropia

ARTIS-Micropia is the world’s first museum dedicated to the hidden world of microbes, and it’s absolutely amazing; definitely one of the best museums in Amsterdam!
Your visit to ARTIS-Micropia begins with an animated video showing the bacteria living on your eyelashes while you travel in a lift up to the top floor. Once you’re up there, you can look through microscopes at bubbling vats of bacteria, see bioluminescent microorganisms and discover how many microbes live in your belly button.
I loved the wall of petri dishes where Micropia’s resident scientists had cultured a whole range of everyday microbes. Some of them were strangely beautiful, almost like flowers. I wasn’t quite so keen on the dead baby giraffe, but I couldn’t stop looking at the jars showing how different foods decompose.
How to get there: ARTIS-Micropia is right next to the ARTIS Zoo on Plantage Kerklaan. The nearest tram stop is Artis/Holocaust Museum. Google Maps link.
Ticket information: Like the ARTIS-Groote Museum and the ARTIS Zoo, ARTIS-Micropia is included in the I amsterdam city card. The normal entry fee is €17.50.
Tips for visiting: ARTIS-Micropia is recommended for children age 8 and above. If you’re easily upset I recommend skipping the baby giraffe exhibit.
Dutch Resistance Museum (Verzetsmuseum)

The Dutch Resistance Museum really surprised me. I visited because tickets were included in my I amsterdam city card and it was close to the ARTIS museums, but it ended up being one of the best museums I’ve visited in Amsterdam.
The Dutch Resistance Museum describes how the Dutch people reacted to Nazi occupation during World War II. The atmospheric displays bring different aspects of the occupation to life, while the museum uses individual people’s stories to prompt visitors to ask themselves what they would do in the same situation. The moral ambiguity of some of the stories was particularly thought-provoking, and highlighted that none of us really know how we’d react in such an awful situation.

How to get there: The Dutch Resistance Museum (Verzetsmuseum) is opposite the ARTIS complex on Plantage Kerklaan. The nearest tram stop is Artis/Holocaust Museum. Google Maps link.
Ticket information: There’s no need to book a timed slot to visit the Dutch Resistance Museum. Tickets cost €16.00, or entry is free with the I amsterdam city card.
Tips for visiting: The Plantage area of Amsterdam where you’ll find the Dutch Resistance Museum was one of the major Jewish quarters in Amsterdam before World War II. If you’ve visited the Anne Frank museum, the Dutch Resistance Museum is a good companion, along with the nearby National Holocaust Museum and the Jewish Museum.
Museum of the Canals (Grachtenmuseum)

The Museum of the Canals was another Amsterdam museum where I wasn’t sure what to expect, but I ended up finding it absolutely fascinating. Set in an elegant canal house on the Herengracht, the 45 minute long audio and video tour will give you an excellent overview of how Amsterdam developed, why it looks the way it does and what’s underneath the pretty canal house facades (millions of wooden piles).
You need to complete each section of the museum before you can move on, but it’s all so interesting and beautifully done that it held my attention all the way through.

How to get there: The Museum of the Canals is on the Herengracht in the south west of the central canal area. The nearest tram stop is Koningsplein. Google Maps link.
Ticket information: The Museum of the Canals costs €17.50 for adults, but you’ll get in free with an I amsterdam city card.
Tips for visiting: The whole museum is wheelchair accessible, so if you have difficulty with the stairs in most other canal house museums, the Museum of the Canals might be a good option. The free audio guide is available in Dutch, English, German, French, Spanish, Italian, Russian, Japanese and Chinese.
Amsterdam City Archives

The Amsterdam City Archives is a real hidden gem but it absolutely deserves a spot on this list of the best museums in Amsterdam. The archives are in the giant De Bazel building which was built as the headquarters for a bank; the vault now holds a museum about the history of Amsterdam, illustrated with treasures from the archives.
I wanted to visit the museum of the Amsterdam City Archives to see the architecture, but when I was actually there the displays really drew me in, with fascinating old photographs. I particularly loved the displays in the little safety deposit rooms.

How to get there: The Amsterdam City Archives are towards the south of the canal belt, between Muntplein and the Rijksmuseum. The nearest tram stop is Muntplein. Google Maps link.
Ticket information: The permanent exhibition in the vault is free to visit. There’s a ticket fee for the temporary exhibitions.
Tips for visiting: The Amsterdam City Archives are 10 minutes’ walk from the Rijksmuseum and near the beautiful Golden Bend, so it’s easy to combine a quick stop with the other museums in this area.
Our Lord in the Attic Museum (Museum Ons’ Lieve Heer op Solder)

Another literally hidden gem, this time in one of the busiest tourist areas of Amsterdam. The canal house at Oudezijds Voorburgwal 40 looks much the same as its neighbours, but it has a secret. The three top floors conceal a Catholic church, built in the 1660s when it was forbidden to practice any religion other than Protestantism in public.
The Our Lord in the Attic Museum (Museum Ons’ Lieve Heer op Solder) is two museums in one. The lower floors show what life was like for people living in the house in the 1600s, while the church on the upper floors is beautifully preserved and a complete contrast to the house below. The church still holds monthly services in the summer months.

How to get there: The Our Lord in the Attic museum is a couple of streets from Damrak on Oudezijds Voorburgwal. It’s less than 10 minutes’ walk from Centraal Station. Google Maps link.
Ticket information: Tickets for the Museum Ons’ Lieve Heer op Solder cost €16.95 for adults, or entry is free with the I amsterdam city card.
Tips for visiting: While the hidden church is one of the best museums in Amsterdam, the many narrow stairs up to the top floors make it a challenge if you have difficulty walking. If this applies to you, you can book a co-visit, where you can take a virtual tour while a guide goes around the museum with a phone, allowing you to experience the building together.
The Cat Cabinet (KattenKabinet)

If you’re a cat lover like me, don’t miss Het KattenKabinet. The KattenKabinet is a small, quirky museum entirely dedicated to cats in art and culture. It’s set inside a grand 17th-century canal house on the Herengracht, once owned by a wealthy Amsterdam merchant.
Inside, you’ll find paintings, sculptures, posters and even vintage advertisements, all featuring feline subjects. The collection includes works by famous artists such as Picasso, Rembrandt and Toulouse-Lautrec, alongside kitsch cat memorabilia. And of course there are real cats wandering around getting more attention than the art!

How to get there: The Cat Cabinet (Het KattenKabinet) is towards the south of the canal belt. The nearest tram stop is Muntplein.
Ticket information: You can book tickets online but you should be fine just to walk in. Tickets cost €12.50 for adults; you can get a 25% discount with the I amsterdam city card.
Tips for visiting: The KattenKabinet is open every day except Mondays, 12pm to 5pm. This part of the Herengracht is known as the Golden Bend, and it’s one of the most beautiful, exclusive parts of Amsterdam, so it’s worth spending some time taking in the views.
How to group your visits
Amsterdam’s museums are spread across the city, but many of the best museums in Amsterdam are clustered together, making it easy to make the most of your time in the city.
Museumplein area

Museums: Rijksmuseum, Van Gogh Museum, Stedelijk Museum, Moco Museum
The Museumplein is Amsterdam’s “classic” museum area, with four major art museums next to each other. The fancy Pieter Cornelisz Hooftstraat shopping street and leafy Vondelpark are both nearby if you get museumed-out.
Plantage area

Museums: ARTIS-Groote Museum, ARTIS-Micropia, Verzetsmuseum (Dutch Resistance Museum), National Holocaust Museum, Hortus Botanicus, Jewish Cultural Quarter, H’ART Museum, Amsterdam Museum’s temporary home
The leafy Plantage area is full of some of the best museums in Amsterdam. Its wide and elegant avenues, squares and parks are a great contrast to the cobbles of the canal ring, and full of history, in particular Jewish history.
Southern canal belt

Museums: Amsterdam City Archives, KattenKabinet, FOAM, Museum of the Canals, Huis Willet-Holthuysen, Museum Van Loon
The southern segment of central Amsterdam’s canal belt has lots of great museums, many in elegant canal houses. If you’re looking for a day pottering around museums, antique shops and cafes, then this is a lovely part of Amsterdam to explore.
Western canal belt

Museums: Anne Frank House, Houseboat Museum, Van Gogh & Rembrandt in Amsterdam immersive experience
The museums of the western canal belt aren’t super close to each other, but you can explore some of the prettiest canal streets in Amsterdam as you walk between them, go shopping in the Jordaan area or find a cosy cafe for some apple pie.
Oosterdok

Museums: NEMO Science Museum, Maritime Museum
The Oosterdok area is just to the east of Amsterdam’s Centraal Station and is full of both history and interesting modern sights. This area, together with the islands further east, was the main dock for Amsterdam in the 1800s, the base for the Dutch Admiralty, and where sailing ships were built during the 17th and 18th century.
Today the area is vibrant with everything from big company HQs to urban farms and even an open water swimming area with sauna.
Amsterdam Noord

Museums: Eye Filmmuseum, STRAAT Museum, Nxt Museum
Amsterdam Noord on the north side of the IJ river is one of the most rapidly developing areas in Amsterdam, thanks at least in part to the museums, galleries and other attractions that have sprung up in the area over the last decade.
The GVB ferries from the dock outside Centraal Station are the easiest way to get over to Noord; the one to the A’DAM Lookout and Eye Filmmuseum runs every few minutes, 24 hours a day.
Tips for visiting Amsterdam’s museums
Book early
The Anne Frank House and Van Gogh Museum need to be booked several weeks in advance. The Rijksmuseum can also sell out. I like an early slot as they’re quieter and it’s easier to see the exhibits compared to later in the day.
Save money and see more with the I amsterdam city card
The I amsterdam city card includes free or discounted entry to almost every museum in Amsterdam, and during my trips to Amsterdam I’ve always found that having the card helps me see more of the city.

There are a couple of significant exceptions; the Van Gogh Museum and Anne Frank House aren’t covered at all. Some museums require you to book a free timeslot even if you hold the I amsterdam pass.
I’ve written a full review of the I amsterdam city card, based on my experience using both the digital and physical versions of the card during my last three trips to Amsterdam, and comparing the overall savings of using the city card vs paying for attraction tickets and transport individually.
Take your time
Some of these Amsterdam museums can be intense and deeply affecting. Mix in canal walks, cafes and lighter sightseeing to recharge and reflect – or take one of the great day trips from Amsterdam for a change of scene.
Final thoughts
Amsterdam’s brilliant museums are one of the city’s biggest draws, and with so much variety there’s something for every interest. Whether you want to admire great art from the Dutch Golden Age, understand how your body works or explore the history of cinema, you’ll find it in Amsterdam.
Tell me which Amsterdam museums you love in the comments!

About Helen
Hi! I’m Helen, and I’ve visited Amsterdam and the Netherlands multiple times. I really love Amsterdam but I always tell people not to sleep on the rest of the Netherlands as there’s so much else to see! You can see my other posts from the Netherlands here.
I live near Manchester, UK and work full time, so I’m all about making the most of my annual leave with day trips, weekend getaways and short breaks.
Pin it for later!









